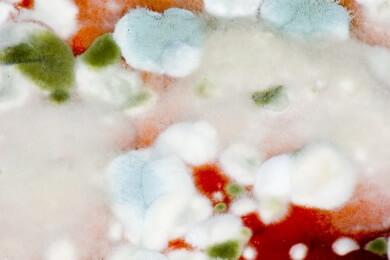
Hausmittel gegen Schimmel verursachen weniger Nebenwirkungen

Hausbau News
Alle Kurzmeldungen zum Thema Hausbau.
Wer stolzer Besitzer eines Eigenheims werden möchte, hat im Vorfeld jede Menge Dinge zu planen. Angefangen beim Grundstückskauf bis hin zur Auswahl des Bauunternehmens für den Hausbau und die Entscheidung ob Fertighaus, Massivhaus oder Passivhaus.
175 Kurzmeldungen zum Thema
- Sanierungsmaßnahmen: Was darf man als Eigentümer und was steigert den Wert der Wohnung?
Wer eine Eigentumswohnung für den Verkauf fit machen möchte, überlegt sich vorab, welche Sanierungsschritte sinnvoll wären. Immerhin sollen ...
![Sanierungsmaßnahmen: Was darf man als Eigentümer und was steigert den Wert der Wohnung?]()
- Tipps und Tricks für Heimwerker zum richtigen Tapezieren
Bei der Wohnungsrenovierung zählt das Tapezieren der Wände neben dem Streichen zu den häufigsten Tätigkeiten. Damit der Tapetenwechsel ...
![Tipps und Tricks für Heimwerker zum richtigen Tapezieren]()
- Wie sich Bauherren gegen Pfusch und Mängel am Bau absichern können
Mängel und Pfusch am Bau sind der Alptraum jedes Häuslebauers. Zu dem Ärger über die Schäden kommt auch noch die Auseinandersetzung mit dem ...
![Wie sich Bauherren gegen Pfusch und Mängel am Bau absichern können]()
- Bewusst leben: Wirkung der Wandfarbe in Wohnräumen nicht unterschätzen
Viele Menschen stecken viel Zeit und Energie in das Dekorieren ihrer Wohnung. Die Möbel werden ausgesucht und Bilder an die Wand gebracht. Auch ...
![Bewusst leben: Wirkung der Wandfarbe in Wohnräumen nicht unterschätzen]()
- Tipps und Infos zum Bau von Fertighäusern
Fertighäuser sind die preiswerte und schnelle Alternative zu Einfamilienhäusern aus Stein. Doch die Zeiten vorgefertigter Ware sind längst ...
![Tipps und Infos zum Bau von Fertighäusern]()
- Altersgerechter Umbau von Wohnung oder Haus muss nicht teuer sein
Wenn Menschen älter werden, stehen auf einmal neue Lebensentscheidungen an. Sie müssen sich auch überlegen, wo sie leben möchten. Es ist ...
![Altersgerechter Umbau von Wohnung oder Haus muss nicht teuer sein]()
- Tausch eines Grundstücks nach voreiliger Erbteilung unterliegt der Grunderwerbsteuer
Tauschen Mitglieder einer Erbengemeinschaft ererbte Grundstücke, müssen sie anschließend Grunderwerbsteuer zahlen. Das hat das Finanzgericht ...
![Tausch eines Grundstücks nach voreiliger Erbteilung unterliegt der Grunderwerbsteuer]()
- Hilfe beim Hausbau: Was Bauberater bieten und wie viel sie kosten
Bauherren müssen viele Entscheidungen treffen: ob Planung Finanzierung Eigenleistung Bauüberwachung oder Gewährleistung; Experten ...
![Hilfe beim Hausbau: Was Bauberater bieten und wie viel sie kosten]()
- BGH stärkt Rechte von Mietern bei Schönheitsreparaturen
Immer wieder kommt es zwischen Mietern und Vermietern zu Auseinandersetzungen, wer Schönheitsreparaturen in einer Immobilie durchführen muss. ...
![BGH stärkt Rechte von Mietern bei Schönheitsreparaturen]()
- Welche baulichen Veränderungen Mieter vornehmen dürfen
Wenn Mieter ihre Wohnung nach eigenen Vorstellungen gestalten möchten, müssen sie einige Dinge beachten. So ist es ihnen nicht gestattet, ...
![Welche baulichen Veränderungen Mieter vornehmen dürfen]()
- So finden Bauherren eine seriöse Baufirma
Der Bau eines eigenen Hauses ist für viele Menschen ein großer Wunsch. Doch durch die Wahl der falschen Baufirma kann aus einem Traum schnell ...
![So finden Bauherren eine seriöse Baufirma]()
- Temperaturen entscheiden über Hausbau im Winter
Über einen milden Winter freuen sich alle Häuslebauer. Liegen die Temperaturen dagegen unter fünf Grad Celsius drohen Schäden am Bau. Vor ...
![Temperaturen entscheiden über Hausbau im Winter]()
- Chancen und Risiken der Wärmedämmung von Häusern
Die Deutschen sollen weniger Energie verbrauchen und ihre Häuser besser dämmen. Dies ist das Ziel des Bundesregierung. Der CO2-Ausstoß soll ...
![Chancen und Risiken der Wärmedämmung von Häusern]()
- Peinlicher Patzer beim Hausbau - Pärchen errichtet Villa auf falschem Grundstück
Ein amerikanisches Paar hat seine Traumvilla mit Meerblick und Pool auf dem falschen Grundstück errichtet. Das 680.000 Dollar teure Haus sollte ...
- Risse in der Wand - harmlos oder gefährlich?
Risse in der Wand sehen nicht nur störend aus - sie können auch gefährlich werden. Aber wie unterscheidet man harmlose Putzrisse und tiefere ...
![Risse in der Wand - harmlos oder gefährlich?]()
- Mit Erbpacht zum eigenen Haus - Erbbaurecht als Alternative zum Grundstückskauf
Ein Eigenheim zu bauen, war selten so beliebt wie heute. Die niedrigen Zinsen sind ein großer Anreiz, in die eigenen vier Wände zu ziehen. Aus ...
![Mit Erbpacht zum eigenen Haus - Erbbaurecht als Alternative zum Grundstückskauf]()
- Wärme, Ruhe und Sicherheit - Tipps und Informationen zum Fensterkauf
Bei der Wahl neuer Fenster spielen neben ästhetischen Gesichtspunkten auch funktionale Aspekte eine wichtige Rolle. So sollte der ...
![Wärme, Ruhe und Sicherheit - Tipps und Informationen zum Fensterkauf]()
- Wann lohnt sich eine energieeffiziente Wärmedämmung?
In Zeiten wo die Strompreise stetig steigen, denkt der eine oder andere Immobilienbesitzer über eine energieeffiziente Sanierung nach, welche ...
![Wann lohnt sich eine energieeffiziente Wärmedämmung?]()
- Durch eine Dämmung der Kellerdecke kann man bis zu sieben Prozent der Energie einsparen
Wie der Energieexperte der Verbraucherzentrale Nordrhein-Westfalen, Achim Fischer erklärt, kann man durch eine Dämmung der Kellerdecke fünf ...
- Was man beim Ausbessern von Fassaden beachten sollte
Der Winter ist vorbei und jetzt beginnt auch für Hausbesitzer die Zeit um sich für die Außenfassade zu kümmern, die manchmal durch Frost und ...
- Schimmel in der Wohnung vorbeugen - kleine Flecken rasch selbst entfernen
Schimmelbefall in den eigenen vier Wänden ist ein weit verbreitetes Problem. Rund 17 Prozent der deutschen Haushalte sind davon betroffen, wie ...
![Schimmel in der Wohnung vorbeugen - kleine Flecken rasch selbst entfernen]()
- Hausmittel gegen Schimmel verursachen weniger Nebenwirkungen
Die österreichische Zeitschrift "Konsument" hat jetzt einmal die verschiedenen Mittel gegen Schimmelbildung getestet. Oftmals kommt es in den ...
![Hausmittel gegen Schimmel verursachen weniger Nebenwirkungen]()
- Wie man eine Modernisierung oder Sanierung einer Immobilie finanzieren kann
Besitzer von Immobilien müssen grundsätzlich auch an die Zukunft denken und für eine eventuelle Sanierung oder Renovierung vorsorgen. Bei ...
![Wie man eine Modernisierung oder Sanierung einer Immobilie finanzieren kann]()
- Zahlreiche Grundstücke der Deutschen Bahn mit Altlasten und Giftstoffen verseucht
Die Deutsche Bahn AG besitzt zahlreiche Grundstücke in ganz Deutschland. Dazu zählen alle eigentlichen Bahnanlagen, wie etwa Gleise, Bahnhöfe ...
- Vier Säulen für eine solide Immobilienfinanzierung - was Bauherren und Käufer bedenken sollten
Der Traum vom Eigenheim kann derzeit für viele Bundesbürger zur Realität werden: Niedrige Zinsen und gute Konjunkturaussichten lassen auch ...
![Vier Säulen für eine solide Immobilienfinanzierung - was Bauherren und Käufer bedenken sollten]()
- Mit Hausmitteln gegen Schimmelflecken - so klappt es auch ohne Chemie
In der kalten Jahreszeit haben Schimmelflecken an den Wänden Hochkonjunktur. Häufig ist die Ursache beim Lüften zu suchen, aber auch eine ...
![Mit Hausmitteln gegen Schimmelflecken - so klappt es auch ohne Chemie]()
- Bdw klärt in der aktuellen Dezemberausgabe über gängige Mythen in Bezug auf die Gebäudedämmung auf
In Deutschland sollen Häuser bis spätestens zum Jahr 2050 hin energetisch optimiert werden. Da aber selbst Expertenmeinungen in Bezug auf den ...
- Mit buntem Licht gegen Schimmelpilze - Forscher entwickeln neue Waffe gegen Pilzbefall
Forscher vom Karlsruher Max Rubner-Institut rücken Schimmelpilze ins rechte Licht. Als die Biologen zufällig entdeckten, dass Pilze unter ...
- BGH entscheidet gegen bunte Wände - Mieter müssen Wohnung in neutralen Farben hinterlassen
Farbe bringt Leben ins Haus. Solange ein Mietvertrag läuft, dürfen die Mieter ihre Wohnung deshalb nach eigenem Geschmack streichen. Wer ...
- Wohnen im Denkmal - was Eigentümer bei Sanierungen beachten sollten
In den letzten Monaten wurden bundesweit tausende Gebäude als Denkmäler anerkannt. Für die Eigentümer ist das mit zahlreichen Auflagen ...
![Wohnen im Denkmal - was Eigentümer bei Sanierungen beachten sollten]()
- Bei Schimmelbildung ist häufig der Mieter verantwortlich
Schimmelbefall in der Wohnung kann verschiedene Ursachen haben. Meist entstehen die schwarzen Flecken an den Wänden jedoch durch falsche ...
- Neue Fenster sparen Energie - entscheidend ist der U-Wert
Neue Fenster können den Wärmeverlust eines Gebäudes reduzieren. Entscheidendes Kriterium bei der Auswahl ist der U-Wert. Je niedriger dieser ...
![Neue Fenster sparen Energie - entscheidend ist der U-Wert]()
- Wenn der Handwerker pfuscht - drei Gebote für Auftraggeber
Fehler passieren überall. Damit die Auseinandersetzung mit dem Handwerker nicht in Frust und finanziellem Fiasko endet, sollte der Auftraggeber ...
- Hartz-IV-Behörde will Krebskranke nicht beim Umzug aus ihrer Schimmel-Wohnung unterstützen
Eine gelernte Krankenschwester aus Walsleben musste sich wegen einer Brustkrebserkrankung einer Operation und mehreren Chemotherapien ...
- Bauherren haben bei Schwarzarbeit keine Garantie für eine eventuelle Mängelbeseitigung
Seit dem Jahr 2004 gibt es ein Gesetz zur Bekämpfung der Schwarzarbeit. Wie jetzt ein Urteil des Bundesgerichtshof (BGH) zeigt, gibt es bei ...
- Energiesparen für Hausbesitzer - Tipps für Wärmedämmung von Gebäuden
Um Energie zu sparen, werden immer mehr Häuser gedämmt. Bei einer Dämmung der Außenwände fallen jährlich 8000 bis 9000 Kilowattstunden ...
![Energiesparen für Hausbesitzer - Tipps für Wärmedämmung von Gebäuden]()
- Wie die Farbe, so das Wohlbefinden - Tipps für die passende Wandfarbe zuhause
Wer in eine neue Wohnung einzieht oder einen Raum auch einfach nur renovieren möchte, stellt sich früher oder später die Frage, in welcher ...
![Wie die Farbe, so das Wohlbefinden - Tipps für die passende Wandfarbe zuhause]()
- Styling für das Wohnzimmer des 21.Jahrhunderts: Tapete mit LED-Lichtdesign
Wandtattoos und Fototapeten waren gestern: Der Wandtapete mit LED-Leuchten gehört die Zukunft. Zumindest wenn es nach dem German Design Council ...
- Makler dürfen auch bei halbem Kaufpreis die volle Courtage kassieren
Die Maklercourtage ist immer wieder Thema von Streitigkeiten. In einem Urteil hat das Oberlandesgericht Hamm nun die Ansprüche der Makler ...
- Schimmel in den eigenen vier Wänden richtig beseitigen
In der freien Natur kommt Schimmel sehr oft vor. Gesundheitsschädlich wird dieser erst dann, wenn er sich in der Wohnung angesiedelt hat. ...
- Neuartiger Beton UHCP ist so fest und beständig wie Stahl
Für den Bau von Brücken und Gebäuden benötigt man Beton, der aus Zement, Sand und Kies sowie Wasser hergestellt wird. Aber leider hält ...
- Krise sorgt für Boom - Dachdecker profitieren von Investitionen in wertstabile Geldanlagen
Aufgrund der permanenten Krisenlage haben viele Bundesbürger Angst ihr sauer erspartes Geld von einem Tag auf den anderen zu verlieren. Deshalb ...
- Baugeld dank niedriger Zinsen günstig wie nie - Immobilien in deutschen Großstädten immer teurer
Das finanzielle Auf und Ab auf den internationalen Finanzmärkten beschert Hausbauern und Hauskäufern momentan extrem niedrige Zinsen für ...
- Duisburg-Bruckhausen will über 120 Häuser für neuen Grüngürtel abreißen
Im Duisburger Stadtteil Bruckhausen leben heute viele arme Menschen und Ausländer, von denen viele im nahe gelegenen Stahlwerk bei Thyssen ...
- Männer erledigen kleinere Reparaturaufgaben erst nach sechs Monaten
Bis Männer sich einmal dazu aufraffen und Arbeiten erledigen, die im Hause anfallen, kann es schon mal länger dauern, zumindest wenn es um ...
- Deutsche fürchten sich vor Schimmel in Lebensmitteln und Chemie im Essen
Viele Bundesbürger fühlen sich in ihren eigenen vier Wänden nicht sicher. Sie haben Angst, dass Schimmel und Chemikalien ihre Gesundheit ...
- Verstärkte Schimmelgefahr durch langen Winter
Der Winter in diesem Jahr war nicht nur besonders kalt, sondern vor allem auch besonders lang. Die meisten Menschen haben ihre Heizungen deshalb ...
- Architekt in Rente baut Traumbaumhäuser für Kinder in den USA
Der pensionierte Architekt James Curvan aus Texas, USA, nutzt seine Rente, um endlich kreativere Arbeiten ausüben zu können. Während der ...
- In Düsseldorf verursacht eine Alarmanlage fast 800 Euro Telefonkosten
Ein Ehepaar aus Düsseldorf hatte sich kurz vor seinem Urlaub am Mittelmeer eine teure Alarmanlage einbauen lassen, um seine Luxus-Wohnung vor ...
- Bebauungsplan prüfen: Vor dem Grundstückkauf sollte man die Auflagen kennen
Drum prüfe, wer sich ewig bindet - dieser Grundsatz gilt nicht nur bei der Heirat, sondern auch beim Bauen. Wer auf der Suche nach einem ...
- Lüftungsanlagen gegen Schimmelbildung
In manchen Wohnungen kommt es zu einer Schimmelbildung, weil die Wohnungen nicht regelmäßig gelüftet werden. Besonders dichte Fenster, die ...
- Wohnungbau in Deutschland nimmt wieder zu
Nachdem der Wohnungsbau hierzulande im Jahr 2009 seinen Tiefpunkt mit rund 136.000 neuen Wohnungen erreichte, werden jetzt wieder mehr Wohnungen ...
- Urhistorischer Fund bei Ausgrabungen im Kölner Opern-Viertel
Bei Bauarbeiten im Opern-Viertel in Köln haben Wissenschaftler einen historischen Fund gemacht. Bei ihren Ausgrabungen stießen sie auf ...
- Kim Kardashian und Kanye West suchen Ferienhäuser in Europa
Kim Kardashian und Kanye West haben bereits ein riesiges Anwesen in Kalifornien, doch das Paar möchte sich nun angeblich noch einige ...
- Bauzaun muss sämtlichen Witterungsbedingungen standhalten
Da ein Bauzaun vorbeifahrende Fahrzeuge beschädigen oder Personen verletzen kann, muss er laut einem Urteil des Amtsgericht München ...
- Geologisches Gutachten bei Neubauten bietet Schutz
Nah an der Oberfläche liegendes Grundwasser sowie weiche Böden oder steile Hanglagen bergen unter Umständen große Gefahren wie Risse oder ...
- Auch im Winter die Wohnung richtig lüften
Auch im Winter sollte man in der Wohnung die Fenster zum Lüften kurz weit auf machen, denn dies ist besser als das Fenster nur auf "Kipp" zu ...
![Auch im Winter die Wohnung richtig lüften]()
- Kim Kardashian baut ihr Haus um
Die Diva Kim Kardashian und ihr Verlobter Kanye West haben bereits alles, was man sich nur erträumen lassen kann. Zum Beispiel eine Villa in ...
- Blue Hole Bay auf den Bahamas - Loch für 24 Millionen Dollar zu verkaufen
Wer schon immer ein 200 Meter tiefes Loch sein eigen nennen wollte, kann nun auf den Bahamas zuschlagen: Dort steht mit Blue Hole Bay das ...
![Blue Hole Bay auf den Bahamas - Loch für 24 Millionen Dollar zu verkaufen]()
- Deutschland bebaut seine Grünflächen - Jeden Tag verschwinden 81 Hektar
Immer mehr Wälder, Wiesen und Weiden in Deutschland werden bebaut. An jedem Tag wächst die Fläche für Häuser, Straßen oder Sportplätze um ...
![Deutschland bebaut seine Grünflächen - Jeden Tag verschwinden 81 Hektar]()
- Explosiver Fund zu Silvester: Thüringer bunkert 600 Granaten im Garten
Unter einem Silvesterböller stellen sich die meisten etwas anderes vor: In Thüringen wurde ein Mann am Silvesterabend schwer verletzt, als er ...
- England - 25-Jährige gestaltet komplett pinkes Haus nach Geburt ihres Sohnes in Blautönen
Jeder Mensch hat wohl eine Farbe, die ihm am meisten zusagt. Die 25-jährige Engländerin Wanda Matthews ist allerdings so sehr in ihre ...
- Immer mehr Pfusch am Bau
Für viele Bauherren ist es der reine Horror, so dass oftmals der Traum vom schönen Eigenheim wie eine Seifenblase zerplatzt. Der Grund dafür ...
- Dieter Bohlen designt jetzt Tapeten
Ob Sänger, Produzent, Jury-Mitglied oder Werbegesicht, Dieter Bohlen hat viele Talente. Jetzt versucht sich der Pop-Titan auch noch als ...
- Schimmel in der Wohnung vermeiden
Nicht selten kommt es in der Wohnung zur Entstehung von Schimmelpilzen. Werden diese über Sporen verbreitet, gelangen sie in unsere Atemwege ...
- Was man beim Kauf eines Baugrundstücks beachten sollte
Für den Bau eines Hauses braucht man ein dementsprechendes Baugrundstück. Dabei sollte man aber einige Dinge beachten, so steht zuerst einmal ...
![Was man beim Kauf eines Baugrundstücks beachten sollte]()
- Google-Menschen nun auch in echt zu sehen
Google Street View ist vielen Menschen ein Begriff. Es werden Bilder in Städten aufgenommen, die dann im Internet zu sehen sind. Paolo Cirio, ...
- Österreich: Ein Wildschwein spielt "Bankräuber"
An diesem Schwein können sich Bankräuber ein Beispiel nehmen. Am 22. Juni dieses Jahres bemerkte ein Putzfrau im Foyer der Raiffeisenbank im ...
- Sanierung des Eigenheims nur eingeschränkt von der Steuer absetzbar
Während Vermieter die Kosten der Modernisierung ihres Eigenheims steuerlich absetzen können, klappt dies bei den Selbstnutzern nicht so ...
- Grün wie der Hulk: Brasilianer kriegt die Farbe nicht mehr ab
Er ist stark, wild und grün: der Hulk. Paulo Henrique dos Santos, Bademeister und Sänger aus Rio de Janeiro, begeisterte sich so für die ...
- Der Sommerhitze trotzen: Sonnenschutzglas lässt die Wärme draußen
Wenn im Sommer die Sonne ins Zimmer scheint und die Raumluft übermäßig aufheizt, dann ziehen viele Menschen die Jalousien vor und sperren das ...
- Schlechte Aussichten für Menschen, die neu bauen wollen
Zur Zeit beten viele Finanzämter Bauherren doppelt zur Kasse. Sowohl beim Erwerb des Baugrundstücks als auch für die Fertigstellung des ...
- Stiftung Warentest - Alpinaweiß ist die beste Wandfarbe
Wer seine Wände wegen mangelnder Deckkraft der Farbe nicht noch ein zweites Mal streichen will, der sollte besser gleich zu einer etwas ...
![Stiftung Warentest - Alpinaweiß ist die beste Wandfarbe]()
- Lehmhäuser setzen radioaktive Isotope frei - Gesundheitliche Folgen durch Strahlung
Als ökologischer Baustoff hat Lehm eine lange Tradition sowie Symbolkraft. Allerdings ist der Baustoff nicht ganz ungefährlich und kann sogar ...
- Evakuierung wegen Spielzeug-Granate in New York
Der Ground Zero in New York erinnert täglich an die schlimmen Vorkommnisse im Jahre 2001. Genau gegenüber dieses denkwürdigen Ortes wurde im ...
- Preise für Neubauten werden in Deutschland immer teurer
Für den Neubau von Wohngebäuden muss man seit Februar dieses Jahres deutlich mehr zahlen, was besonders für den Dämmschutz sowie Holz- und ...
- Marienkäfer scheuchen Polizei auf
In der 2. Fußball-Bundesliga dümpelt Traditionsklub Karlsruher SC am Tabellenende herum. Doch am Dienstag gab es Punkte, sogar sehr viele ...
- EU-Parlament will neue Richtlinie durchsetzen - Hausbesitzer müssen zwangssanieren
Das EU-Parlament in Brüssel will eine neue Richtlinie durchsetzen, nach der alle Wohnungs- und Hausbesitzer ihre Immobilie energetisch sanieren ...
- Wenn es beim Hausbau zu Fehlern kommt
Wie die Richter vom BGH entschieden haben, dürfen Bauherren einen Teil der Baukosten zurückbehalten, wenn das Haus mit Mängeln übergeben ...
- Wie vermeidet man Schimmel im Neubau?
Heute wird selbst im Winter in den Neubauten gearbeitet, weil die Baumaterialien anders als früher sind und die Anbieter von Schlüsselfertigen ...
- Kamera als Schutz vor den eigenen vier Wänden?
Wie die Richter vom Bundesgerichtshof nun entschieden haben, darf ein Eigentümer von einem Reihenhaus in bestimmten Fällen das Haus per Kamera ...
- Jonathan Adler: Interieur-Designer macht jetzt in Mode
Ob Planet Hollywood in Las Vegas oder die Villa eines berühmten Millionärs: US-Amerikaner Jonathan Adler hat vielen Räumen seine ganz ...
- Kameraüberwachung des Eigenheims wird immer beliebter
Hausbesitzer haben ihre Immobilie heutzutage dank modernster Kameraüberwachung jederzeit genau im Blick. Während man vor einigen Jahren noch ...
- Raumausstatter findet Gesicht von Jesus an einer Wand
Der 37-jährige Raumausstatter Sam Dalby aus England hatte vor kurzem einen ganz besonderen Arbeitstag. Er hatte mit dem Umbau einer Scheune zu ...
- Schimmelalarm in deutschen Wohnungen
Wie das Portal für Immobilien immowelt.de berichtet hat, gibt es in fast 20 Prozent aller deutschen Wohnungen Schimmelflecken. Oft sind diese ...
- Für Wohneigentümer gelten neue Regeln
Damit die Klimaziele der Regierung erreicht werden, sollen nun auch Hauseigentümer neue Regeln treffen. Wird das Haus saniert oder renoviert, ...
- Einfarbig ist passé - die Einrichtung zeigt wieder Muster
Heutzutage vermittelt man sein Selbstverständnis auch in der Einrichtung seiner Wohnung. Die Zeiten in denen alles aus einem Guss war, scheinen ...
![Einfarbig ist passé - die Einrichtung zeigt wieder Muster]()
- Schimmelbildung im Winter - Haushaltsreiniger hilft
Wenn im Winter das Kondenswasser von innen an den Fensterscheiben entlang läuft, sollte man schnell zum Lappen greifen. Als Vorbeugung gegen ...
![Schimmelbildung im Winter - Haushaltsreiniger hilft]()
- Indien - "The sky is the limit" - Kalkutta soll blauen Anstrich bekommen
Kalkutta, Indien, soll bald komplett blau angestrichen werden, wie der dortige Chief Minister angeordnet hat. Damit soll sich das Stadtbild der ...
- Lehm als Wandputz sorgt für bessere Luft
Schon seit Jahrhunderten wird Lehm als Baumaterial verwendet, so wurden auch im alten Ägypten zum Bau der Pyramiden Lehmziegel verwendet. Aber ...
- Fliesenleger entdeckt Goldschatz
Handwerk hat goldenen Boden, lautet ein bekanntes Sprichwort. In Hannover erfuhr ein Fliesenleger am eigenen Leib, was dieser Satz bedeutet. Bei ...
- Spatz wird auf der Flucht vor der Kälte zum Wiederholungstäter
Die Eiseskälte in Deutschland hält Mensch und Tier fest im Griff. Kein Wunder, dass ein Platz im Warmen derzeit heiß begehrt ist. Auch ein ...
- Wie man beim Traum von Eigenheim Kosten sparen kann
Wie eine Forsa-Umfrage im letzte Jahr ergab, träumen etwa mehr als drei Viertel der Deutschen von einem Eigenheim. Dabei möchte aber nur ein ...
![Wie man beim Traum von Eigenheim Kosten sparen kann]()
- Bauherren sollten mit den Handwerkern feste Termine festlegen
Damit es nicht zu Ärger mit den Handwerkern bei den Fertigstellungsterminen kommt, sollten private Bauherren diese vorher vertraglich ...
- China: Plattenbau in Rekordzeit
Innerhalb von nur 15 Tagen hat eine Baufirma in der chinesischen Provinz Hunan ein 30-stöckiges Hotel errichtet. Da das Unternehmen ...
- Schimmelpilze im Badezimmer können zum Problem werden
In der amerikanischen Fachzeitschrift "Journal of Clinical Microbiology" wurde eine Studie veröffentlicht, bei der die Häufigkeit des ...
- Parkett muss immer richtig gepflegt werden
Damit Parkett immer schön bleibt, muss er richtig gepflegt werden. Je nach Farbe und Holzart des Parketts, empfiehlt sich ein passendes Öl, ...
![Parkett muss immer richtig gepflegt werden]()
- Banken geben Selbstständigen ungern einen Immobilienkredit
Wer Bauen oder eine gebrauchte Immobilie kaufen will, der benötigt meistens auch einen Immobilienkredit. Um diesen aber von den Banken ...
![Banken geben Selbstständigen ungern einen Immobilienkredit]()
- Fehlalarm - Besitzer muss für Polizeieinsatz zahlen
Wenn die Alarmanlage an einem Haus oder Auto grundlos anspringt und die Polizei umsonst kommt, muss der Besitzer für die Kosten des Einsatzes ...
- Allergiker sollten beim Hausbauen auf die verwendeten Baumaterialien achten
Wie der Verband Privater Bauherren (VPB) berichtet, sollten Allergiker, bevor sie ein schlüsselfertiges Haus bauen lassen, dem Anbieter eine ...